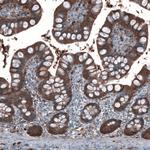
ALDH1A1 Antibody in Immunohistochemistry (Paraffin) (IHC (P))

Search
Invitrogen
ALDH1A1 Polyclonal Antibody
{{$productOrderCtrl.translations['antibody.pdp.commerceCard.promotion.promotions']}}
{{$productOrderCtrl.translations['antibody.pdp.commerceCard.promotion.viewpromo']}}
{{$productOrderCtrl.translations['antibody.pdp.commerceCard.promotion.promocode']}}: {{promo.promoCode}} {{promo.promoTitle}} {{promo.promoDescription}}. {{$productOrderCtrl.translations['antibody.pdp.commerceCard.promotion.learnmore']}}
产品信息
PA5-110653
种属反应
宿主/亚型
分类
类型
抗原
偶联物
形式
浓度
规格
纯化类型
保存液
内含物
保存条件
运输条件
RRID
产品详细信息
Immunogen sequence: IYDEFVRRSV ERAKKYILGN PLTPGVTQGP QIDKEQYDKI LDLIESGKKE GAKLECGGGP WGNKGYFVQP TVFSNVTDEM RIAKEEIFGP VQQIMKFKSL DDVIKRANNT FYGL
Highest antigen sequence indentity to the following orthologs: Mouse - 91%, Rat - 90%.
靶标信息
ALDH1A1 belongs to the aldehyde dehydrogenases family of proteins. Aldehyde dehydrogenase is the second enzyme of the major oxidative pathway of alcohol metabolism. Two major liver isoforms of this enzyme, cytosolic and mitochondrial, can be distinguished by their electrophoretic mobilities, kinetic properties, and subcellular localizations. Most Caucasians have two major isozymes, while approximately 50% of Orientals have only the cytosolic isozyme, missing the mitochondrial isozyme. A remarkably higher frequency of acute alcohol intoxication among Orientals than among Caucasians could be related to the absence of the mitochondrial isozyme.
仅用于科研。不用于诊断过程。未经明确授权不得转售。
篇参考文献 (0)
生物信息学
蛋白别名: 3-deoxyglucosone dehydrogenase; acetaldehyde dehydrogenase 1; aldehyde dehydrogenase 1 (EC 1.2.1.3); Aldehyde dehydrogenase 1 soluble; aldehyde dehydrogenase 1, soluble; Aldehyde dehydrogenase 1A1; Aldehyde dehydrogenase family 1 member A1; Aldehyde dehydrogenase, cytosolic; aldehyde dehydrogenase, liver cytosolic; ALDH class 1; ALDH-E1; ALHDII; epididymis luminal protein 12; epididymis luminal protein 9; epididymis secretory sperm binding protein Li 53e; epididymis secretory sperm binding protein Li53e; MGC2318; oxidoreductase; RALDH 1; Retinal dehydrogenase 1; retinaldehyde dehydrogenase 1; unnamed protein product
基因别名: ALDC; ALDH-E1; ALDH1; ALDH11; ALDH1A1; HEL-9; HEL-S-53e; HEL12; PUMB1; RALDH1
UniProt ID: (Human) P00352
Entrez Gene ID: (Human) 216